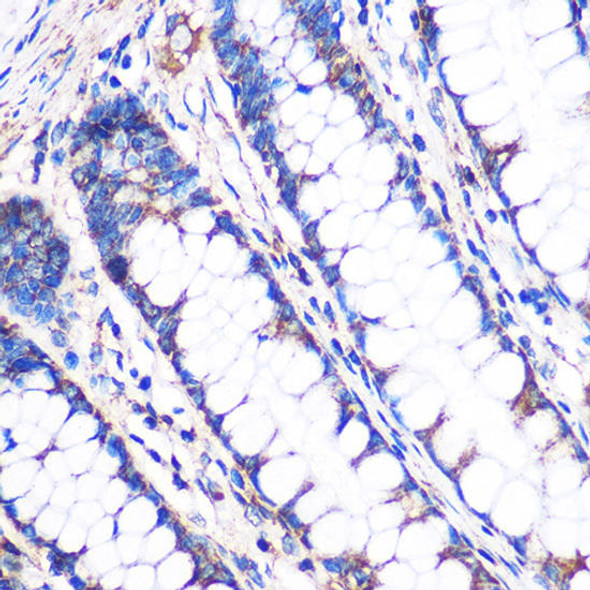
NDUFA4L2 Rabbit Polyclonal Antibody (CAB14288)

Description
| Product Name: | Human NDUFA4 Recombinant Protein |
| Product Code: | RPPB2004 |
| Size: | 20µg |
| Species: | Human |
| Target: | NDUFA4 |
| Synonyms: | NDUFA4, Mitochondrial Complex Associated, NADH-UbiquinoneOxidoreductase MLRQ Subunit, NADH Dehydrogenase (Ubiquinone) 1 AlphaSubcomplex, 4, 9kDa, Complex I 9kDa Subunit, Complex I-MLRQ, CI-MLRQ, NADHDehydrogenase (Ubiquinone) 1 Alpha Subcomplex, 4 (9kD, MLRQ), NADH Dehydrogenase[Ubiquinone] 1 Alpha Subcomplex Subunit 4, CI-9k, MLRQ, Cytochrome c oxidasesubunit NDUFA4. |
| Source: | Escherichia Coli |
| Physical Appearance: | Sterile Filtered colorless solution. |
| Formulation: | NDUFA4 protein solution (1mg/ml) containing 20mM Tris-HClbuffer (pH 8.0), 10% glycerol and 0.4M Urea. |
| Stability: | Store at 4°C if entire vial will be used within 2-4 weeks.Store, frozen at -20°C for longer periods of time. For long term storage it is recommended to add a carrier protein (0.1% HSA or BSA).Avoid multiple freeze-thaw cycles. |
| Purity: | Greater than 80% as determined by SDS-PAGE. |
| Amino Acid Sequence: | MGSSHHHHHHSSGLVPRGSH MGSMLRQIIGQAKKHPSLIP LFVFIGTGAT GATLYLLRLA LFNPDVCWDR NNPEPWNKLG PNDQYKFYSV NVDYSKLKKERPDF |
NADH Dehydrogenase1 Alpha Subcomplex 4 (NDUFA4) is a member of the complex I 9kDa subunit family. Mammalian complex I of mitochondrial respiratory chain is comprised of 45 different subunits. NDUFA4 protein has NADH dehydrogenase activity and oxidoreductase activity. NDUFA4 transfers electrons from NADH to the respiratory chain. The immediate electron acceptor for the NDUFA4 enzyme is assumed to be ubiquinone.
NDUFA4 Human Recombinant produced in E.Coli is a single,non-glycosylated polypeptide chain containing 104 amino acids (1-81 a.a) andhaving a molecular mass of 11.8kDa.NDUFA4 is fused to a 23 amino acid His-tag at N-terminus& purified by proprietary chromatographic techniques.
| UniProt Protein Function: | NDUFA4: Accessory subunit of the mitochondrial membrane respiratory chain NADH dehydrogenase (Complex I), that is believed to be not involved in catalysis. Complex I functions in the transfer of electrons from NADH to the respiratory chain. The immediate electron acceptor for the enzyme is believed to be ubiquinone. Belongs to the complex I NDUFA4 subunit family. |
| UniProt Protein Details: | Protein type:Oxidoreductase; Energy Metabolism - oxidative phosphorylation; EC 1.6.5.3; Mitochondrial; EC 1.6.99.3 Chromosomal Location of Human Ortholog: 7p21.3 Cellular Component: mitochondrial inner membrane; mitochondrial respiratory chain complex I; mitochondrial respiratory chain complex IV; mitochondrion Molecular Function:cytochrome-c oxidase activity; protein binding; protein complex binding Biological Process: mitochondrial electron transport, cytochrome c to oxygen |
| NCBI Summary: | The protein encoded by this gene belongs to the complex I 9kDa subunit family. Mammalian complex I of mitochondrial respiratory chain is composed of 45 different subunits. This protein has NADH dehydrogenase activity and oxidoreductase activity. It transfers electrons from NADH to the respiratory chain. The immediate electron acceptor for the enzyme is believed to be ubiquinone. [provided by RefSeq, Jul 2008] |
| UniProt Code: | O00483 |
| NCBI GenInfo Identifier: | 2499333 |
| NCBI Gene ID: | 4697 |
| NCBI Accession: | O00483.1 |
| UniProt Secondary Accession: | O00483,Q6FHN5, A4D109, |
| UniProt Related Accession: | O00483 |
| Molecular Weight: | 9,370 Da |
| NCBI Full Name: | Cytochrome c oxidase subunit NDUFA4 |
| NCBI Synonym Full Names: | NDUFA4, mitochondrial complex associated |
| NCBI Official Symbol: | NDUFA4�� |
| NCBI Official Synonym Symbols: | MLRQ; CI-9k; CI-MLRQ�� |
| NCBI Protein Information: | cytochrome c oxidase subunit NDUFA4 |
| UniProt Protein Name: | Cytochrome c oxidase subunit NDUFA4 |
| UniProt Synonym Protein Names: | Complex I-MLRQ; CI-MLRQ; NADH-ubiquinone oxidoreductase MLRQ subunit |
| Protein Family: | Cytochrome c oxidase |
| UniProt Gene Name: | NDUFA4�� |
| UniProt Entry Name: | NDUA4_HUMAN |